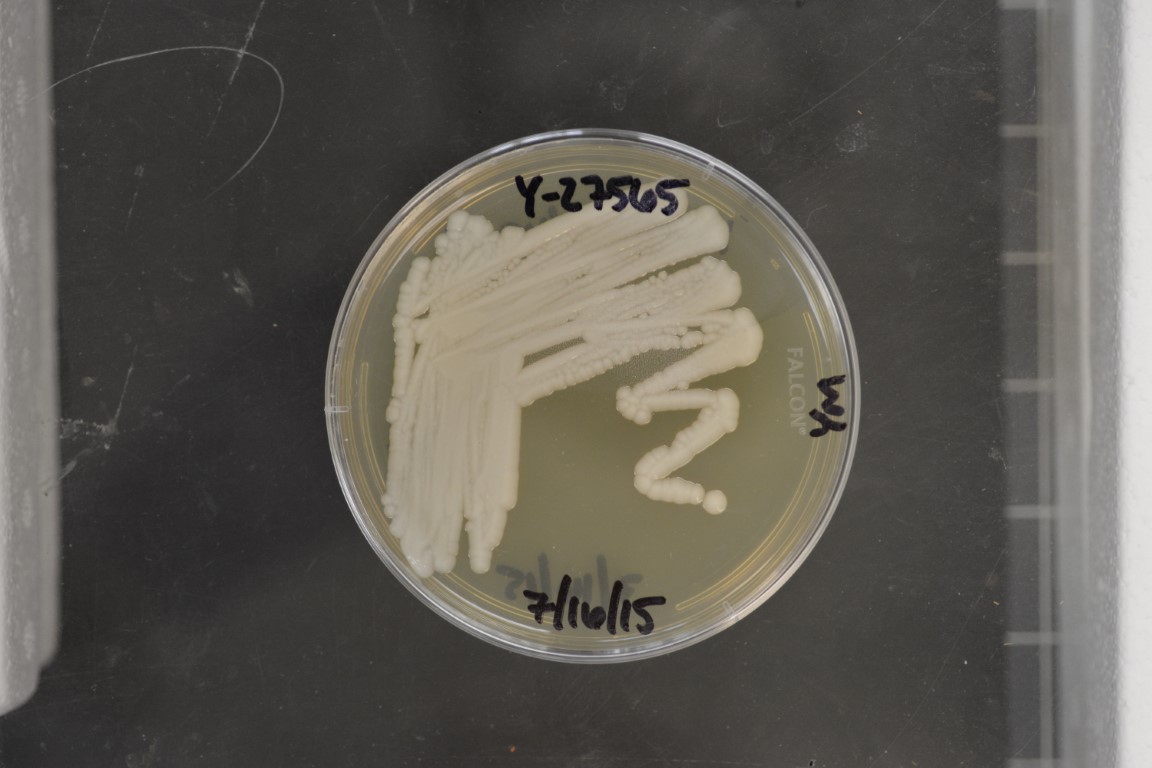

Suhomyces ambrosiae
NRRL Y-27565
Accession numbers in other collections:LSU BG 99-8-11-1-C2
Source:Sung-Oui Suh/Meredith Blackwell,Louisiana State Univ.,Baton Rouge,LA
Isolated from(substrate):IN,beetle,Megalodacne fasciata(Erotylidae)ex Ganoderma applanatum
Substrate location:Memorial Park,Athens,Georgia,USA
Genetic info:GenBank AY242153 and AY242262.
Growth media:Yeast Extract-Malt Extract-Peptone-Glucose(YM for yeasts)(number 6)
Optimum growth temperature:25C
Strain images:
NRRL_Y-27565_6.jpg